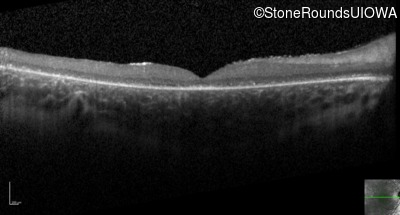
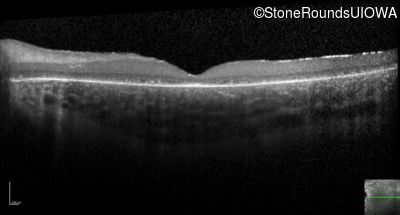
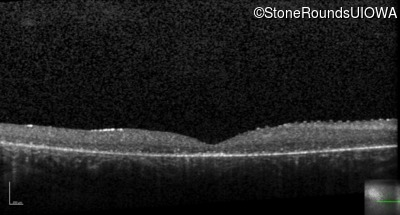
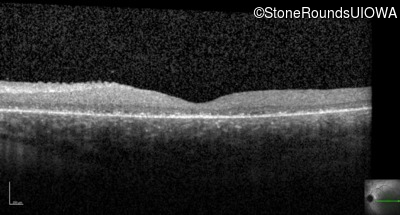
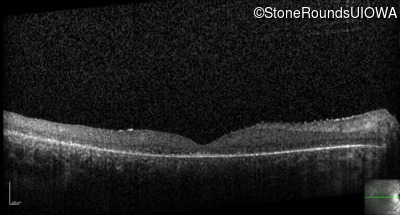
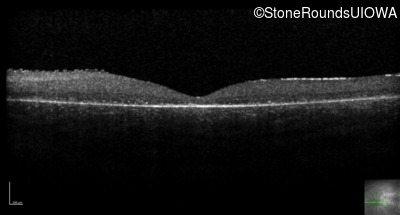
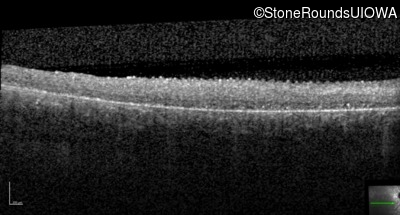
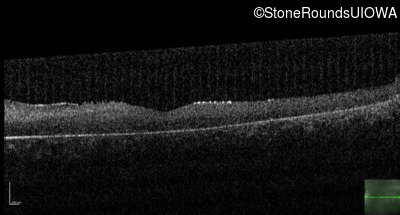

Case
SR74
Student Mode
Batten Disease (IB3)
Male
Male
Hidden
SR74
Student Mode
Batten Disease (IB3)
Male
Male
Visit at age: 7 years
Fundus Photography - Right - 20/200 sc
Exemplar

Fundus Photography - Left - 10/160 sc
Exemplar

Optical Coherence Tomography - Right - 20/200 sc
Exemplar / OCT Stack

OCT Stack

Optical Coherence Tomography - Left - 10/160 sc
Exemplar / OCT Stack

OCT Stack

Infrared Fundus Photograph - Right - 20/200 sc
Exemplar

Infrared Fundus Photograph - Left - 10/160 sc
Exemplar

Visit at age: 7 years (Visit 2)
Optical Coherence Tomography - Right - <1/700 sc
Exemplar / OCT Stack

OCT Stack

Optical Coherence Tomography - Left - 3/200 sc
Exemplar / OCT Stack

OCT Stack

Infrared Fundus Photograph - Right - <1/700 sc
Exemplar

Infrared Fundus Photograph - Left - 3/200 sc
Exemplar

Visit at age: 8 years
Optical Coherence Tomography - Right - <1/700 sc
Exemplar / OCT Stack

OCT Stack

Optical Coherence Tomography - Left - <1/700 sc
Exemplar / OCT Stack

OCT Stack

Infrared Fundus Photograph - Right - <1/700 sc
Exemplar

Infrared Fundus Photograph - Left - <1/700 sc
Exemplar

Visit at age: 9 years
Optical Coherence Tomography - Right - No Light Perception
Exemplar / OCT Stack

OCT Stack

OCT Stack

OCT Stack

OCT Stack

OCT Stack

Optical Coherence Tomography - Left - No Light Perception
Exemplar / OCT Stack

OCT Stack

OCT Stack

Infrared Fundus Photograph - Right - No Light Perception
Exemplar

Infrared Fundus Photograph - Left - No Light Perception
Exemplar

Visit at age: 11 years
Optical Coherence Tomography - Right - No Light Perception
Exemplar / OCT Stack

OCT Stack

OCT Stack

Optical Coherence Tomography - Left - No Light Perception
Exemplar / OCT Stack

OCT Stack

OCT Stack

OCT Stack

Infrared Fundus Photograph - Right - No Light Perception
Exemplar

Infrared Fundus Photograph - Left - No Light Perception
Exemplar

Case Level Images
Diagnosis & molecular findings
| Disease |
Gene |
Allele 1 variant(s) |
Allele 2 variant(s) |
Inheritance mode |
| Batten Disease |
PPT1 |
Thr75Pro ACC>CCC |
IVS6-1 G>T |
AR |
Allele 1:
Thr75Pro ACC>CCC
False Genotype Rate:
Gene Count:
Submit Final Diagnosis
Clear Diagnosis